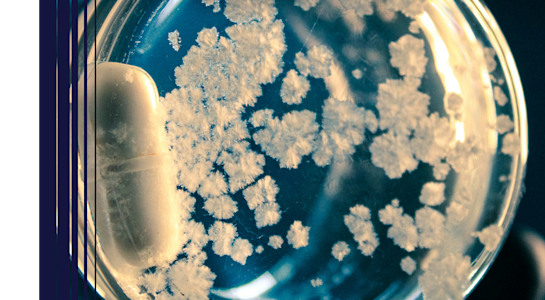
OakxFAIRR AMR video Thumbnail

Quarterly Update
Multiple themes
3 mins | 17 December 2025
FAIRR's Updates: October to December 2025
An overview of recent launches, new investor members, and key milestones from the last three months
Learn MoreFAIRR at COP30
Interviews
Multiple Topics
FAIRR at COP30 | Interview with Professor Shenggen Fan, China Agricultural University
11 December 2025
Interviews
Multiple Topics
FAIRR at COP30 | Interview with Mitch Reznick, Federated Hermes
11 December 2025
Interviews
Multiple Topics
FAIRR at COP30 | Interview with Lasse Bruun, UN Foundation
11 December 2025
Celebrating 10 Years of FAIRR
Featured Videos
Research
AMR
FAIRR x Professor Dame Sally Davies | Inspiring Action on Antimicrobial Resistance
17 November 2025
Partnership with CFA Institute
Interviews
Interviews
Multiple Topics
FAIRR at COP30 | Interview with Lasse Bruun, UN Foundation
11 December 2025
Interviews
Multiple Topics
FAIRR at COP30 | Interview with Professor Shenggen Fan, China Agricultural University
11 December 2025
Interviews
Multiple Topics
FAIRR at COP30 | Interview with Mitch Reznick, Federated Hermes
11 December 2025
FAIRR at PRI in Person
Events
Events
Multiple Topics
FAIRR X PRI in Person 2025 Side Event | Financing a Just Transition for the Agri-Food Sector
4 November 2025
Engagement Findings

Phase 2 | Protein Diversification Engagement Progress Video
Phase 3 | Waste & Pollution Engagement Progress Video

Phase 1 | Seafood Traceability Engagement Progress Video

Phase 2 | Waste and Pollution Engagement Progress Video

Phase 3 | Working Conditions Engagement Progress Video

Working Conditions Engagement Phase 2 | Key Takeaways
Alternative Proteins
Phase 2 | Protein Diversification Engagement Progress Video
Learn more about the findings from the Phase 2 progress report.
Biodiversity
Phase 3 | Waste & Pollution Engagement Progress Video
Learn more about the findings from the Phase 3 progress report.
Biodiversity
Phase 1 | Seafood Traceability Engagement Progress Video
Learn more about the findings from the Phase 1 progress report.
Biodiversity
Phase 2 | Waste and Pollution Engagement Progress Video
Learn more about the findings from the Phase 2 progress report.
Social Risk
Phase 3 | Working Conditions Engagement Progress Video
Learn more about the findings of the Phase 3 Progress report.